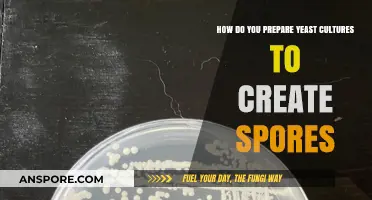
Mastering Yeast Sporulation: A Step-by-Step Guide to Culturing Spores

Opening the console in *Spore* allows players to access debug commands and cheats, enhancing their gameplay experience. To do so, you must first enable the console by modifying the game’s configuration file. Navigate to the *Spore* installation directory, locate the *UserSettings.xml* file, and add the line `
| Characteristics | Values |
|---|---|
| Platform | PC (Windows/Mac) |
| Console Command | Ctrl + Shift + C (Windows) / Cmd + Shift + C (Mac) |
| Functionality | Opens the in-game console for cheat codes and debugging |
| Availability | Available in all game stages (Cell, Creature, Tribal, Civilization, Space) |
| Cheat Code Entry | Type commands directly into the console after opening it |
| Example Commands | addDNA, money, createvehicle, etc. |
| Game Version | Works in all versions of Spore, including Spore Galactic Adventures |
| Developer Mode | Console access is part of the game's built-in developer tools |
| Official Support | Supported by Maxis as a feature for advanced players |
| Risk | Using cheats may affect achievements and game balance |
Explore related products
What You'll Learn
- Using Keyboard Shortcuts: Press `Ctrl + Shift + C` to open the console in Spore
- Console Commands List: Access cheats and debug tools via the in-game console interface
- Troubleshooting Console: Ensure the game is updated and mods aren’t blocking console access
- Console in Different Modes: The console works in all game modes, including Space Stage
- Disabling Console: Close the console by pressing `Esc` or re-entering the shortcut

Using Keyboard Shortcuts: Press `Ctrl + Shift + C` to open the console in Spore
In the realm of Spore, a game celebrated for its creativity and complexity, accessing the console can unlock a treasure trove of possibilities. For those seeking to tweak settings, debug issues, or simply experiment with commands, the keyboard shortcut `Ctrl + Shift + C` is your gateway. This combination, though seemingly simple, is a powerful tool that bridges the gap between standard gameplay and advanced customization.
Mastering this shortcut begins with understanding its mechanics. Unlike some games where console access is buried in menus or requires external tools, Spore keeps it straightforward. Pressing `Ctrl + Shift + C` simultaneously while in-game instantly brings up the console interface. This method is not only efficient but also intuitive, aligning with common keyboard conventions for developer tools. For players accustomed to shortcuts, this approach feels natural, streamlining the process of accessing advanced features without disrupting the flow of gameplay.
However, leveraging this shortcut effectively requires a bit of caution. The console in Spore is a double-edged sword—it grants immense control but demands responsibility. Entering incorrect commands or modifying critical settings can alter your game in unintended ways. To mitigate risks, start by familiarizing yourself with basic console commands and their effects. Online resources and community forums often provide lists of safe and useful commands, offering a starting point for experimentation. Additionally, always save your game before making significant changes, ensuring you can revert if something goes awry.
For those new to console usage, begin with simple commands to build confidence. For instance, typing `help` into the console displays a list of available commands, while `givecash [amount]` adds specified funds to your civilization. These small steps not only demonstrate the console’s potential but also highlight its practicality in enhancing your gaming experience. As you grow more comfortable, you can explore more complex commands, such as modifying creature traits or altering environmental conditions, pushing the boundaries of what’s possible in Spore.
In conclusion, the `Ctrl + Shift + C` shortcut is more than just a key combination—it’s a key to unlocking Spore’s full potential. By balancing curiosity with caution and starting with simple commands, players can harness the console’s power to enrich their gameplay. Whether you’re troubleshooting, customizing, or simply exploring, this shortcut serves as a testament to Spore’s depth and the endless possibilities it offers to those willing to delve deeper.
Botulinum Spores: Unlocking Potential Therapeutic Benefits and Applications
You may want to see also

Console Commands List: Access cheats and debug tools via the in-game console interface
To unlock the full potential of Spore's in-game console, players must first enable the developer console by modifying the game's configuration file. This involves navigating to the game's installation directory, locating the 'Spore.ini' file, and adding the line 'EnableConsole = 1' under the [Debug] section. Once activated, pressing the tilde (~) key during gameplay will open the console interface, providing access to a plethora of console commands. These commands serve as a gateway to cheats, debug tools, and hidden features, allowing players to manipulate various aspects of the game, from creature attributes to world events.
The console commands in Spore are categorized into several groups, each tailored to specific gameplay aspects. For instance, the 'creature' category includes commands like 'setAge' and 'setHealth', enabling players to adjust their creature's age and health status. Similarly, the 'world' category offers commands such as 'setPopulation' and 'setResource', which can be used to modify the population and resource levels of a given planet. It is essential to exercise caution when using these commands, as excessive manipulation may lead to unintended consequences, such as game instability or unbalanced gameplay. Players are advised to save their progress frequently and use console commands judiciously to maintain a balanced and enjoyable gaming experience.
From a practical standpoint, mastering Spore's console commands requires a combination of experimentation and familiarity with the game's mechanics. Players can start by testing commands in a controlled environment, such as a newly created game or a saved file specifically designated for experimentation. As they become more comfortable with the commands, they can gradually incorporate them into their regular gameplay, using them to overcome challenging situations or explore hidden features. It is worth noting that some commands may have limited applications or require specific conditions to function correctly. For example, the 'addSkillPoint' command can only be used during the creature stage, while the 'setAlignment' command requires the player to be in the space stage.
A comparative analysis of Spore's console commands reveals a unique blend of creativity and functionality. Unlike traditional cheat codes, which often provide a temporary advantage, Spore's console commands offer a more nuanced approach to gameplay manipulation. By allowing players to adjust specific attributes and parameters, the commands encourage experimentation and creativity, fostering a sense of ownership and investment in the game world. Furthermore, the debug tools accessible via the console interface provide valuable insights into the game's underlying mechanics, enabling players to better understand the relationships between different gameplay elements. This, in turn, can lead to more informed decision-making and a deeper appreciation for the game's complexity.
In conclusion, Spore's console commands list is a treasure trove of hidden features and debug tools, waiting to be discovered by intrepid players. By providing access to cheats and gameplay manipulation options, the console interface empowers players to shape their gaming experience according to their preferences. However, with great power comes great responsibility, and players must exercise caution when using console commands to avoid disrupting the game's balance. With practice and patience, mastering Spore's console commands can unlock new dimensions of gameplay, offering a fresh perspective on this classic game. As players delve deeper into the world of Spore, they may find that the console commands list is not just a collection of cheats, but a gateway to a more immersive, engaging, and personalized gaming experience.
From Spore to Plant: Unveiling the Growth Journey of Adult Flora
You may want to see also

Troubleshooting Console: Ensure the game is updated and mods aren’t blocking console access
Outdated game versions and conflicting mods are the silent culprits behind many failed attempts to access Spore's console. Before diving into complex fixes, ensure your game is updated to the latest version. Developers often patch issues related to console functionality, so running an older version might leave you stuck. Navigate to your game library on the platform you purchased Spore from (Steam, Origin, etc.), right-click the game, and select "Check for Updates" or "Properties" to verify its version. If an update is available, install it and restart the game to see if the console now responds.
Mods, while enhancing gameplay, can inadvertently block console access by altering core game files or conflicting with console commands. If you’ve recently installed mods, temporarily disable them to isolate the issue. Access your mod manager or manually remove mod files from the game directory, then relaunch Spore and attempt to open the console. If successful, reintroduce mods one by one, testing console access after each addition to pinpoint the problematic mod. Some mods, particularly those affecting UI or scripting, are common offenders.
For a systematic approach, create a backup of your game files before troubleshooting. This ensures you can revert changes if needed. After updating the game, clear the cache or verify the integrity of game files through your platform’s built-in tools. On Steam, for example, right-click Spore, go to "Properties," select "Local Files," and click "Verify Integrity of Game Files." This process repairs corrupted files that might interfere with console functionality.
If updates and mod management don’t resolve the issue, consider reinstalling the game. A fresh installation eliminates residual files or settings that could be blocking console access. Before reinstalling, ensure all mods and custom content are removed to avoid reintroducing conflicts. After reinstallation, test the console without mods to confirm the issue is resolved, then cautiously reintroduce mods if desired. This method, though time-consuming, often provides a clean slate for troubleshooting persistent problems.
Wireless Printing on a Hot Spot: Tips and Tricks for Success
You may want to see also
Explore related products

Console in Different Modes: The console works in all game modes, including Space Stage
The Spore console, a powerful tool for players seeking to tweak and enhance their gameplay, is accessible across all game modes, from the humble Cell Stage to the vast expanse of Space Stage. This universality is a key feature, allowing players to experiment with cheats, debug issues, or simply explore the game's mechanics in any environment. Whether you're nurturing your first multicellular organism or commanding an intergalactic empire, the console remains a constant companion, ready to be summoned with a simple keystroke.
Accessing the Console: A Universal Command
Regardless of your current stage in Spore's evolutionary journey, opening the console follows the same straightforward process. On PC, press the ` (backtick) key, typically located below the Esc key. For Mac users, the process is slightly different; you'll need to press Option + `. This consistency in access ensures that players can seamlessly transition between stages without worrying about changing control schemes. It's a small but significant detail that contributes to the game's overall accessibility.
Console Commands in Space Stage: Expanding Possibilities
In the Space Stage, the console becomes an even more valuable asset. With the ability to manipulate various aspects of your empire, you can accelerate your progress, experiment with different strategies, or simply have fun with the game's physics. For instance, the `addmoney` command can provide a financial boost, while `addtool` allows you to acquire new tools instantly. More advanced players might explore commands like `setinfluence`, which directly impacts your empire's influence over other species. These commands not only offer a practical advantage but also encourage creative exploration of the game's vast universe.
Practical Tips for Console Usage
When using the console in any mode, it's essential to exercise caution. While cheats can enhance your experience, they can also disrupt the natural flow of the game. Start with small adjustments and observe their impact before making more significant changes. Additionally, keep a record of the commands you use, especially in the Space Stage, where the consequences of certain actions can be far-reaching. This practice not only helps you understand the game's mechanics better but also ensures that you can replicate successful strategies in future playthroughs.
The Console as a Learning Tool
Beyond its practical applications, the console serves as an educational tool, offering insights into Spore's underlying systems. By experimenting with different commands, players can gain a deeper understanding of how the game's various stages are interconnected. For example, adjusting parameters in the Cell Stage can have subtle effects on later stages, demonstrating the game's intricate balance. This analytical approach not only enhances the gaming experience but also fosters a greater appreciation for the complexity of Spore's design. Whether you're a casual player or a dedicated explorer, the console provides a unique window into the game's inner workings, making it an indispensable feature for anyone looking to get the most out of their Spore adventure.
Spore Rebellion Tactics: Commoners vs. Military and Religious Factions
You may want to see also

Disabling Console: Close the console by pressing `Esc` or re-entering the shortcut
In the realm of *Spore*, the console is a powerful tool for tweaking gameplay, but it can be intrusive if left open. Disabling the console is straightforward: simply press the `Esc` key or re-enter the shortcut (`Ctrl + Shift + C` by default) to close it. This action ensures your screen returns to its normal state, allowing you to focus on the game without distractions. It’s a quick fix that requires no additional settings or menus, making it accessible even in the heat of gameplay.
Analyzing the mechanics behind this feature reveals its practicality. The `Esc` key is universally recognized as a "cancel" or "exit" command in gaming, making it an intuitive choice for closing the console. Re-entering the shortcut, on the other hand, acts as a toggle, providing an alternative method for those who prefer consistency in their key commands. This dual functionality caters to different player preferences, ensuring a seamless experience regardless of the chosen method.
For players experimenting with console commands, knowing how to disable the console efficiently is crucial. Leaving it open can obstruct your view, interfere with UI elements, or accidentally trigger commands. A practical tip is to develop the habit of closing the console immediately after executing a command. This minimizes the risk of errors and keeps your gameplay uninterrupted. Additionally, if you’re teaching others how to use the console, emphasize this step to avoid confusion or frustration.
Comparatively, other games often require navigating through menus or using less intuitive key combinations to close similar interfaces. *Spore*’s approach stands out for its simplicity and player-friendly design. Whether you’re a casual player or a modding enthusiast, the ability to swiftly disable the console enhances your overall experience. It’s a small detail, but one that reflects the game’s focus on accessibility and user control.
Do Points Really Matter in Spore's Tribal Stage? Exploring Gameplay
You may want to see also
Frequently asked questions
To open the console in Spore, press the ~ (tilde) key on your keyboard while in the game.
The tilde key (~) is usually located in the top-left corner of the keyboard, above the Tab key.
The console is primarily available in the PC version of Spore. It may not function in console versions (e.g., PlayStation or Xbox) or mobile versions of the game.
The console allows you to enter cheat codes, modify gameplay, and access debugging tools. For example, you can use commands like `addDNA` or `money` to enhance your experience.
Ensure the game is in focus and no other keybindings are interfering. If it still doesn’t work, check if your keyboard layout or language settings are affecting the tilde key’s functionality.